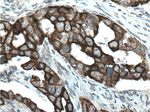
Claudin 4 Antibody in Immunohistochemistry (Paraffin) (IHC (P))

Search
Proteintech
Claudin 4 Polyclonal Antibody
{{$productOrderCtrl.translations['antibody.pdp.commerceCard.promotion.promotions']}}
{{$productOrderCtrl.translations['antibody.pdp.commerceCard.promotion.viewpromo']}}
{{$productOrderCtrl.translations['antibody.pdp.commerceCard.promotion.promocode']}}: {{promo.promoCode}} {{promo.promoTitle}} {{promo.promoDescription}}. {{$productOrderCtrl.translations['antibody.pdp.commerceCard.promotion.learnmore']}}
产品信息
16195-1-AP
种属反应
已发表种属
宿主/亚型
分类
类型
抗原
偶联物
形式
浓度
规格
纯化类型
保存液
内含物
保存条件
运输条件
产品详细信息
This antibody is specifically against claudin 4.
靶标信息
Claudin-4 belongs to the 20-member family of claudins, transmembrane cellular adhesion proteins localized at epithelial and endothelial tight junctions. Claudins demonstrate distinct, tissue-specific expression patterns, and are essential components of tight junction charge-specific channels that regulate paracellular ion flux. Claudin-4 is a component of tight junction strands and may play a role in internal organ development and function during pre- and postnatal life. The overexpression of Claudin-4 has been shown to decrease paracellular electrical conductance due to a selective decrease in Na+ permeability, with no significant decrease in Cl- permeability. In ovarian carcinoma cells, Claudin-3 and Claudin-4 exhibit upregulation at both mRNA and protein levels. Claudin-4 is also overexpressed in pancreatic cancer tissues and cell lines, and in other epithelial cancers. The Claudin-4 gene is deleted in Williams-Beuren syndrome, a neurodevelopmental disorder affecting multiple systems.
仅用于科研。不用于诊断过程。未经明确授权不得转售。
生物信息学
蛋白别名: Claudin-4; CLAUDIN4; Clostridium perfringens enterotoxin receptor; Clostridium perfringens enterotoxin receptor 1; CPE-R; CPE-receptor; h CPE-receptor; unnamed protein product; Williams-Beuren syndrome chromosomal region 8 protein
基因别名: Cep-r; CLDN4; CPE-R; CPER; CPETR; CPETR1; hCPE-R; WBSCR8
UniProt ID: (Human) O14493, (Mouse) O35054
Entrez Gene ID: (Human) 1364, (Rat) 304407, (Mouse) 12740